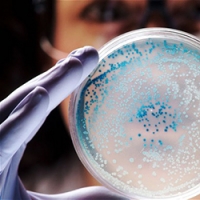

| |
|
|
Пожалуйста, воспользуйтесь нашим прекрасным поиском...
|
|
|
20 августа 2013 года Акне-бактерии против угревой сыпи Зачастую люди, страдающие от угревой сыпи, уверены, что проблемы с кожей существуют только у них, а у всех остальных кожа в прекрасном состоянии. Правда заключается в том, что лишь один человек из пяти никогда не испытывал проблем с акне, а бактерии, вызывающие угревую сыпь, живут на коже абсолютно каждого человека. Ученые из Университета Вашингтона в Сент-Луисе внимательно изучили штаммы P. бактерий, являющихся основной причиной угревой сыпи. Два абсолютно идентичных штамма пропионибактерии были найдены на коже, пораженной акне. У людей же, которые от акне никогда не страдали, этих штаммов обнаружено не было, однако, на их коже присутствовал совершенно иной штамм P. бактерии. Для того чтобы изучить «хорошие» и «плохие» штаммы бактерий, ученые воспользовались обычными полосками для очищения пор кожи. В ходе исследования было замечено, что штаммы бактерий, найденные на пораженных участках кожи, очень отличаются от тех, что «живут» в здоровой коже. Ученые предположили, что тот штамм P. бактерии, который был обнаружен лишь на здоровой коже, работает как естественный защитный механизм. Этот механизм не только реагирует на «плохие» штаммы акне-бактерий, но и уничтожает их. Если предположения ученых верны, «хорошие» штаммы могут быть использованы для создания наиболее эффективных средств против угревой сыпи. Третьяченко Екатерина
Теги: Акне | Исследования
Другие материалы по этой теме:
Материал портала "PlasticReview" Мировая статистика: доходы пластических хирургов и самые популярные пластические операции статьи |
© Независимый портал о косметологии «CosmoPortal.ru» (2007 — 2025). Републикация текстовых и графических материалов сайта возможна только с письменного разрешения администрации. |

















